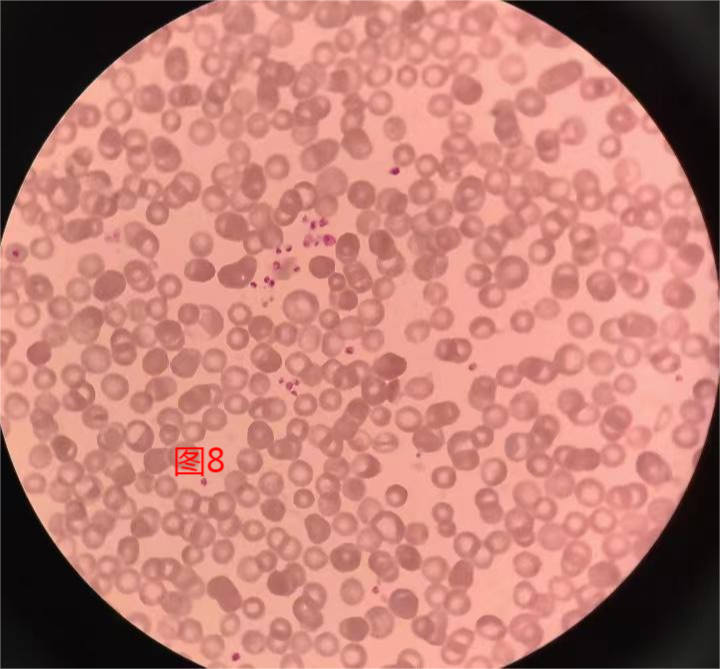

前 言
血小板减少是血常规检测中的常见现象,引起血小板减低的原因主要有病理性因素、药物性因素和技术性因素。无论是病理性还是药物性因素所致的血小板减少,均需要排除技术性因素导致的血小板假性降低,以免对临床诊疗产生不良影响。而涂片染色镜检,正是排除血小板假性降低的不二法门。因此,实验室人员务必要重视涂片染色镜检。
案例经过及分析
案例一
患者,女,46岁,因眼部黄斑水肿到我院眼科就诊,血常规中血小板结果为105×109/L,仪器报警“血小板聚集?”,结果如图1,推片镜检可见血小板聚集,纤维蛋白丝易见,如图2。患者重新釆血后,检测血小板数值为214×109/L,结果如图3。



分析
该患者引起血小板聚集的原因主要是采血不顺利所导致的微凝集。当仪器报警“血小板聚集?” 则触发复检规则,提示需要进行涂片染色镜检。镜下可见血小板成堆聚集且周围有纤维蛋白丝缠绕,片子尾部可见长长的纤维蛋白丝并附着大量血小板。纤维蛋白丝的出现意味着标本存在凝集的可能,这往往是由于采血不顺利引起的微凝集所致,而这种凝集是肉眼无法判断的,只有经过推片镜检才能发现。
案例二
患者,女,53岁,门诊肝胆外科就诊,血常规检测提示血小板17×109/L仪器报警“血小板减少、血小板直方图分布异常、血小板聚集?”,血小板直方图翘尾,如图4。推片镜检可见片子尾部及两侧有成堆、成团聚集的血小板,全片未见纤维蛋白丝,如图5。推测EDTA依赖的可能性大,更换为枸橼酸钠抗凝剂重新采血后,血小板结果为184×109/L,再经计算(PLT为枸橼酸钠抗凝管的检测结果×1.1[2])后发出报告。复检结果如图6。



分析
该患者血小板计数重度减低,仪器报警“血小板减少、血小板直方图分布异常、血小板聚集”,且血小板直方图翘尾,触碰复检规则,血涂片复检镜下可见成堆成团的血小板聚集,并且聚集的血小板都出现在片子尾部及两侧,未见纤维蛋白丝,血小板计数重度减低。此现象最常见于EDTA依赖的血小板假性减低[1]。EDTA依赖的血小板假性减低,一般认为与血清中存在的血小板抗体有关,EDTA使得血小板表面某些隐蔽抗原构象发生改变,进而与其自身抗体结合,导致血小板聚集。
案例三
患者,男,73岁,冠状动脉粥样硬化性心脏病,首次检测血常规血小板数值37×109/L,仪器报警“血小板减少、血小板直方图分布异常”,未报血小板聚集,结果如图7,镜下可见轻度血小板聚集现象,并且这种聚集现象全片易见,如图8。
更换抗凝剂重新釆血后血小板聚集的情况仍然存在,如图9,镜下人工计数估算血小板数值约为72×109/L(估算方法:血小板计数=至少10个油镜视野中血小板平均个数×15)。最后又通过血小板手工计数法计数血小板数量为65×109/L,。以手工计数结果发出报告。

分析
该患者血小板数值37×109/L,仪器报警“血小板减少、血小板直方图分布异常”,触碰复检规则需要涂片复检。血涂片复检镜下可见轻度血小板聚集现象,多为三五个血小板聚集在一起,且这种现象全片均可见,但是浏览整个血片并未发现成团聚集的血小板。
该样本仪器检测血小板计数重度减低,镜下血小板有微聚集,但仪器并未报警血小板聚集。出现这种情况的原因是血球分析仪虽然有聚集的报警提示,但通常只有当聚集强度达到一定的阈值之后仪器才会进行提示,而本例标本并未达到设定的报警阈值,因此仪器并未报警。这种现象往往多见于处于高凝状态的患者,如:孕产妇、心血管疾病等,其原因尚不明确。
总 结
血常规是实验室最基础的检测项目,如何从成百上千的标本中及时发现异常,及时准确的发出报告,最是考验实验室人员的基本功!本文三个案例中仪器检测血小板结果都减低,推片复检镜下均可见不同程度的血小板聚集现象,虽然都有血小板聚集,但是引起聚集的原因却不尽相同,最终的纠正方法也各不相同。本文提示我们,重视仪器的报警信息,切实落实血常规的复检规则,及时识别出可能存在异常的标本!重视涂片染色镜检,熟练掌握相关技能,及时明确血小板减少的原因,进而采取有效的措施以及时发出报告!我们需要谨记,涂片染色镜检和手工计数,这是我们永不过时的金标准!
参考文献:
[1]关向前、陈发珍,EDTA依赖性血小板聚集及其对血小板计数的影响,临床输血与检验2015年6月第17卷第3期
[2]崔巍,续薇,中华医学会检验医学分会血液学与体液学学组.血细胞分析报告规范化指南[J].中华检验医学杂志2020年43卷6期, 619-627页, ISTIC PKU CSCD CA, 2020.
来源:检验医学